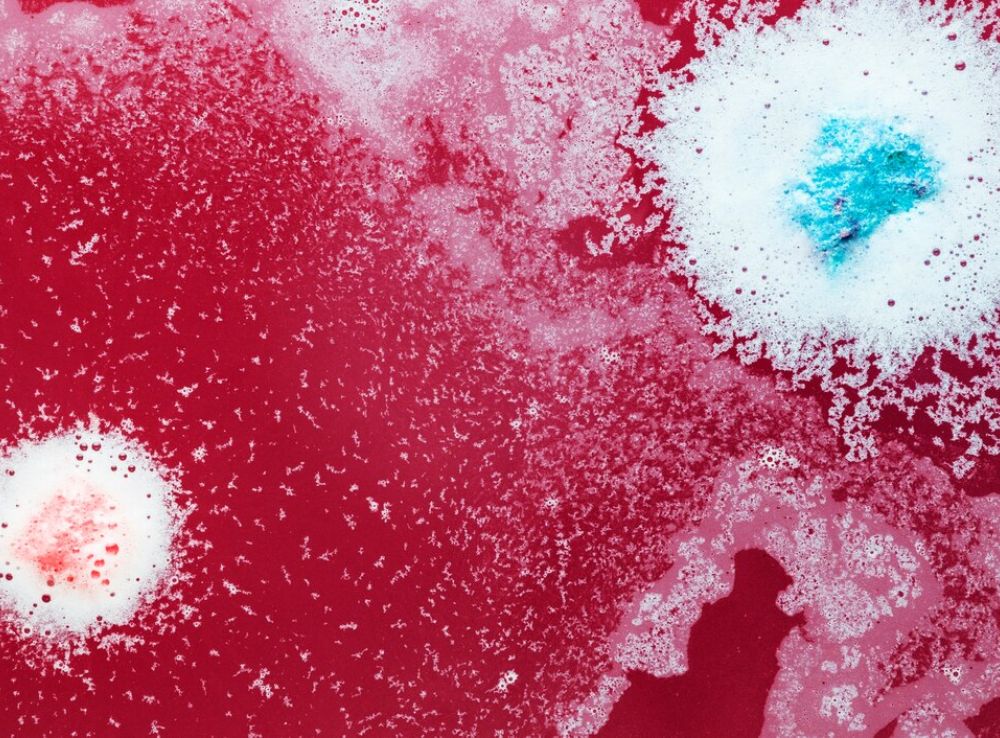

WHAT IS GELATIN?
STEP-by-STEP Production Process

Raw Material Preparation:

Hydrolysis:
Cleaning:

Drying and Grinding:
TYPES of GELATINE

Acidic Gelatin: A Versatile Helper for Desserts

Alkaline Gelatin: The Ideal Choice for Sturdy Structures

Unrefined Gelatin: Natural and Beneficial in Every Grain

Hydrolyzed Gelatin: Energy and Wellness for an Active Life

Zastosowanie Żelatyny
Mapa Europy: Zaznaczone sektory przemysłu (spożywczy, farmaceutyczny, kosmetyczny, fotografia, napoje).
Kliknięcie na sektor wyświetla przykłady zastosowań żelatyny w danej branży wraz z obrazkami i krótkimi opisami.

Title
Title
Title
Naturalness 🌱
Gelatin comes from nature and contains no artificial additives. It is an ideal choice for those who value natural ingredients. Example: “When you enjoy a perfectly springy jelly – it’s gelatin that makes it special.”
Biodegradability 🌍
Care for the environment with gelatin! Thanks to its biodegradability, it leaves no negative impact on our planet.
Example: “Every choice of gelatin-based products is a step towards a sustainable future.”


WHY CHooSe GELATIN?
Versatility 🛠️
From the kitchen to cosmetics – gelatin finds its place almost everywhere.
Example: “Gelatin is the secret to fluffy desserts, safe medicine capsules, and nourishing cosmetic masks.”
Safety ✅
With high production standards, gelatin is completely safe for your health. It’s a natural ingredient you can trust.
Example: “No worries – gelatin-based products meet rigorous quality standards.”



REGULATIONS & STANDARDS
REACH (Registration, Evaluation, Authorization, and Restriction of Chemicals) is a regulation of the European Union aimed at ensuring a high level of protection for human health and the environment from the risks posed by chemicals. It also promotes alternative methods for the hazard assessment of substances to reduce animal testing.
Key points about REACH:
- Requires manufacturers and importers to gather comprehensive information about the properties of their chemical substances.
- Ensures that substances with significant risks are properly controlled or replaced with safer alternatives.
- Applies to all chemical substances used in industrial processes, consumer goods, and everyday products such as paints, cleaning products, and plastics.
HACCP (Hazard Analysis and Critical Control Points) is a systematic preventive approach to food safety. It identifies, evaluates, and controls potential hazards in the food production process to ensure consumer safety.
Key features of HACCP:
- Focuses on preventing biological, chemical, and physical hazards rather than inspecting the final product.
- Widely used in the food and beverage industry to guarantee compliance with international safety standards.
- Ensures safe handling, preparation, and distribution of food products to minimize risks to public health.
HACCP is essential for businesses in the food industry to build trust with consumers and comply with global food safety regulations.
ISO (International Organization for Standardization) is an independent, non-governmental organization that develops and publishes international standards across various industries. These standards ensure quality, safety, and efficiency in products, services, and systems.
Key ISO standards relevant to various industries:
- ISO 9001: Focuses on quality management systems, ensuring that organizations consistently meet customer and regulatory requirements.
- ISO 14001: Provides a framework for effective environmental management systems.
- ISO 22000: Targets food safety management systems, ensuring that food is safe for consumption at all stages of the supply chain.
- ISO 45001: Covers occupational health and safety management systems, protecting workers from workplace risks.
ISO standards are essential for companies seeking to demonstrate their commitment to quality, safety, and sustainability on a global scale.













